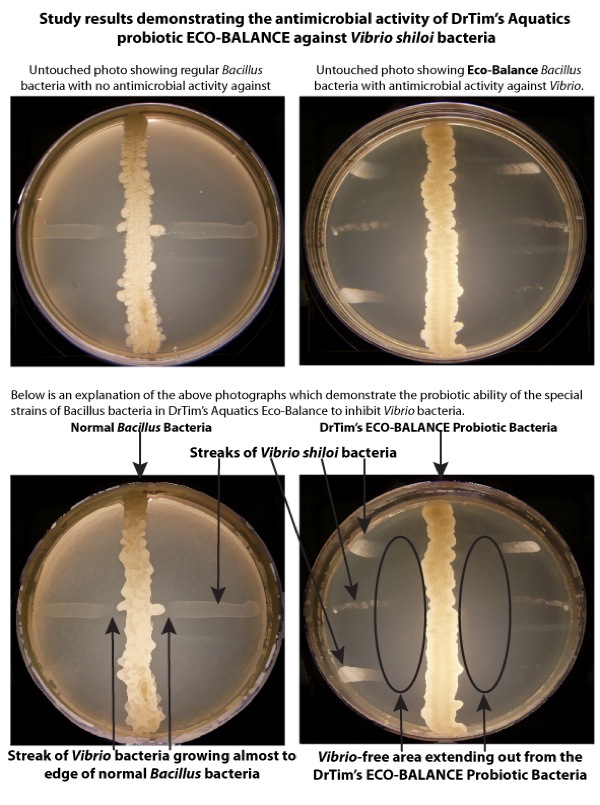

We use cookies to make your experience better. To comply with the new e-Privacy directive, we need to ask for your consent to set the cookies. Learn more.
Dr Tim's Aquatics Eco-Balance 16 fl oz

Dr. Tim's Aquatics Eco-Balance Multi-Strain Probiotic Bacteria for Reef Aquarium 1ea/16 fl ozContains probiotics against coral Vibrios Increase reef water quality & is 100% safe Helps all corals block out unfriendly bacteria Probiotics for Core System Health Research has demonstrated that friendly probiotic bacteria are key to maintaining a balanced, healthy reef aquarium environment. The normal processes in an aquarium upsets this balance which can allow unfriendly bacteria and algae to dominate and this can negatively affect water quality.
Eco-Balance uses friendly reef probiotic bacteria that provide stress relief and enhance the stress resistance of corals and fish. Eco-Balance restores and maintains a balanced reef aquarium environment promoting beneficial bacteria while reducing the number of bad bacteria resulting in a cleaner, healthier reef aquarium. Directions for Use: CAUTION: When using for the first time consider a half-dose as the potent bacteria in Eco-Balance may cause oxygen levels in the water to temporarily drop.
SHAKE WELL BEFORE USING Minimum dose 10 ml per 10 gallons of aquarium water.
- 4 oz bottle treats 120 gallons (454 liters)
- 8 oz bottle treats 240 gallons (908 liters)
- 16 oz bottle treats 480 gallons (1,817 liters)
- 32 oz bottle treats 960 gallons (3,634 liters)
Latest Research Results on Eco-Balance Probiotic Bacteria
Below are some of the research results demonstrating the unique ability of probiotic bacteria, conducted by the researchers at DrTim’s Aquatics. In this case, the study examined the effect unique isolates had on the growth on Vibrio shiloi, a bacterium that has been shown to cause major harm to corals in the wild.
The results shown are just one of many, many trials performed to isolate special strains of Bacillus that showed an ability to inhibit the growth of Vibrio shiloi or other bacteria that can cause problems in aquaria and ponds.
We will update the results and details of our testing on a regular basis to show how real science is put in every product we package.
| Manufacturer | DrTim's Aquatics |
|---|















